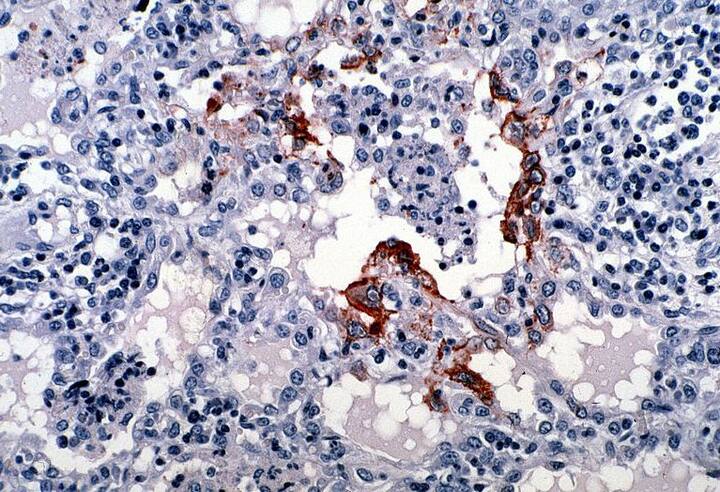
किन्हीं वजहों से अगर आप केरल जा भी रहे हैं तो निपाह वायरस से प्रभावित क्षेत्रों से दूर रहें. फोटोः गूगल फ्री इमेज

एक्सप्लोरर
निपाह वायरसः केरल जाने से बचें, जाना चाहते भी हैं तो इन जगहों पर बिल्कुल ना जाएं
1/6

केरल में निपाह वायरस से अब तक 10 लोगों की मौत हो चुकी है. केरल में कई जगहों पर मेडिकल अलर्ट जारी कर दिया गया है. ऐसे में आपको केरल जाना नजरअंदाज करना चाहिए. फोटोः गूगल फ्री इमेज
2/6

अब तक 13 मामले की पुष्टि हुई है. इसमें 10 लोगों की मौत हो चुकी है. फोटोः गूगल फ्री इमेज
3/6

आपको बता दें, अब तक कोझिकोड और मलप्पुरम जिले में निपाह वायरस की चपेट में आकर 10 लोगों की मौत हो चुकी है और विभिन्न अस्पतालों में 19 लोगों का इलाज हो रहा है. इसमें एक व्यक्ति का उपचार वयनाड में हो रहा है. फोटोः गूगल फ्री इमेज
4/6

स्वास्थ्य सचिव राजीव सदानंदन का कहना है कि राज्य के बाकी हिस्से में जाना सुरक्षित है. अगर लोग अतरिक्त ऐहतियात बरतना चाहते हैं तो वे इन चार जिलों में जाने से बच सकते हैं. फोटोः गूगल फ्री इमेज
5/6

राज्य सरकार ने भी लोगों से केरल राज्य के चार उत्तरी जिलों - कोझिकोड, मलप्पुरम, वयनाड और कन्नूर में जाने से बचने को कहा है. फोटोः गूगल फ्री इमेज
6/6
किन्हीं वजहों से अगर आप केरल जा भी रहे हैं तो निपाह वायरस से प्रभावित क्षेत्रों से दूर रहें. फोटोः गूगल फ्री इमेज
Published at :
और देखें
टॉप हेडलाइंस
हिमाचल प्रदेश
इंडिया
बॉलीवुड
क्रिकेट
























